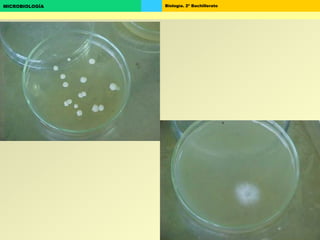
Biología. 2º BachilleratoMICROBIOLOGÍA

Este documento trata sobre la microbiología. Brevemente describe: 1) La microbiología estudia organismos microscópicos como bacterias, virus, hongos y protozoos. 2) Explica la historia del descubrimiento de los microorganismos desde el siglo XVII hasta el desarrollo de la microbiología como ciencia en el siglo XIX. 3) Define conceptos clave como virus, bacterias, hongos, cultivos microbiológicos y los postulados de Koch para el estudio de las enfermedades infecciosas.